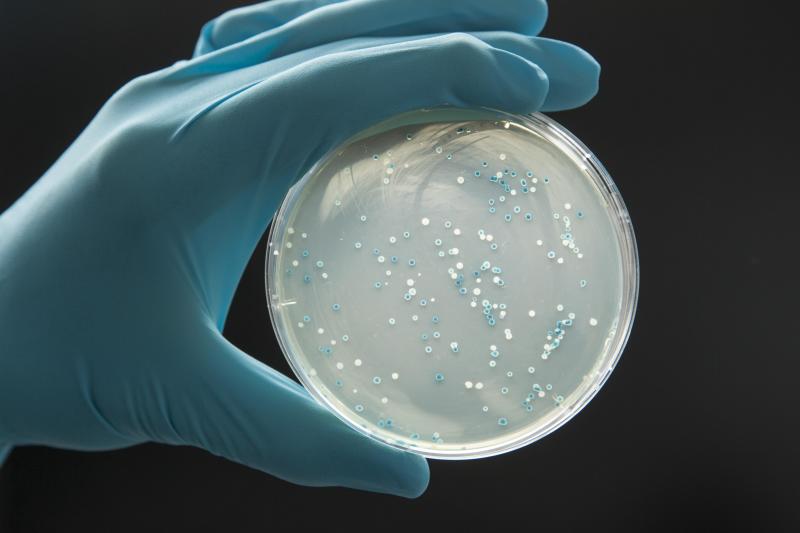

Скрытая угроза: Кишечная палочка в хлебцах и пестициды - в списке 20 торговых марок
Кишечная палочка найдена в хлебцах одной из известных марок. Исследование изделий 20 производителей ржаных хлебцев выявило неожиданный факт - с продукцией "Невской мельницы" не всё в порядке.
Роскачество провело исследование состава ржаных хлебцев 20 торговых марок, оценивая изделия по 453 параметрам безопасности и соответствия маркировке. Среди выбранных брендов были такие, как "О'кей Daily", MaxiVita, Dr.Korner, "Каждый день", Finn Crisp, "Просто", "Щедрые", Kruazett, "Хлебцы-Молодцы", "ОГО!", WASA, "ВкусВилл", "Лента", Magic Grain, Blockbuster, Baker House, Doctor Grain, "Елизавета", "Алтайские хлебцы" и "Невская мельница". Хорошая новость заключается в том, что в результате исследования не было обнаружено токсинов и токсичных элементов, таких как свинец, мышьяк, кадмий и ртуть, ни в одном из продуктов.
 Фото: Andrey Turusov/Russian Look/Globallookpress
Фото: Andrey Turusov/Russian Look/Globallookpress
Однако вызывает беспокойство факт обнаружения кишечной палочки в продукции под маркой "Невская мельница". Это подчёркивает важность контроля за производственными процессами и соблюдение стандартов безопасности. Уточняется, что при производстве изделия проходили термообработку. Предполагается, что микроорганизмы попали в продукт питания уже после того, как он был изготовлен.
Другим важным аспектом исследования была проверка продукции на содержание пестицидов. Хотя вся продукция соответствует обязательным требованиям, в 12 видах хлебцев (торговые марки не раскрываются) были обнаружены следы двух пестицидов. Это напоминает о необходимости внимательного отношения к выбору продуктов и осознанного подхода к питанию.
Фото: Olaf Döring/http://imagebroker.com/search/Globallookpress
Фото: Olaf Döring/http://imagebroker.com/search/Globallookpress
Как уточняет "РИА Новости", наличия кишечной палочки в ржаных хлебцах не допускается. Эти бактерии могут попадать в продукты изначально, однако при правильной термической обработке они погибают. Обнаружение бактерий в хлебцах может свидетельствовать о возможном заражении готовых изделий после производства в процессе транспортировки, упаковки, контакта с оборудованием, руками персонала и другими источниками, пояснила заместитель директора по развитию ФГАНУ "НИИ хлебопекарной промышленности" Олеся Савкина.
У экспертов также не было претензий по запаху и вкусу продукции. Содержание фосфора, калия, магния и железа не вызвало нареканий, однако содержание витаминов В1 и В2 в продукции оказалось невысоким.



























